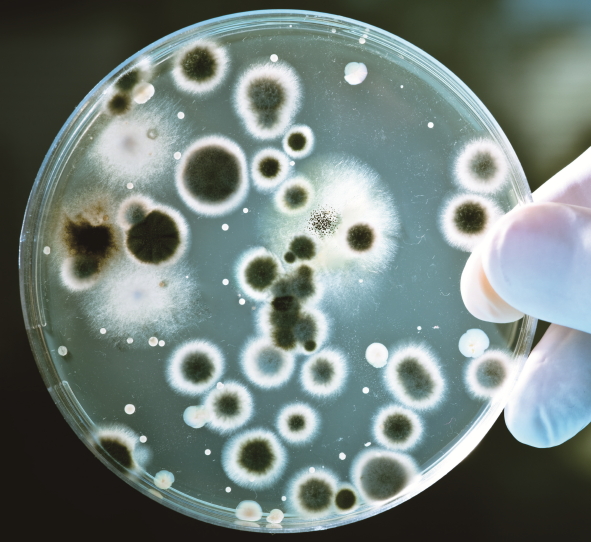

|
ability
|
능력
He has the ability to win the prize
|
|
amazing
|
놀라운
The little boy is an amazing artist

|
|
balance
|
균형
Tim can balance on his toes for a very long time

|
|
behavior
|
행동
Susan's parents were happy with her behavior during the formal dinner
|
|
bend
|
구부리다
Our legs bend at the knees

|
|
circus
|
서커스
These are many acrobats and animals in the circus

|
|
comic book
|
만화책
The artist wants to draw for comic books
|
|
hang
|
걸다
My coat is hanging on the hook beside the door

|
|
hero
|
영웅
His grandfather is his hero

|
|
sword
|
검
Before guns, swords were used in battle

|
|
cape
|
망토
Superman wears a red cape

|
|
career
|
직업
She has enjoyed a long career as a history professor
|
|
costume
|
변장
Susan will wear a witch costume to the party

|
|
curse
|
저주
Many bad things keep happening to Jake, and he thinks it is because of a curse
|
|
dice
|
주사위
Take your turn and roll the dice

|
|
girlfriend
|
여자친구
Nick is holding hands with his girlfriend
|
|
incredible
|
대단한
They enjoyed beautiful beaches and nice weather during their incredible vacation
|
|
producer
|
생산자, 제작자
We need permission from the producer before we can increase spending on the film
|
|
role
|
역할
The auditions for the role of Annie will begin tomorrow at eight o'clock
|
|
wheelchair
|
휄체어
When Gina broke both of her legs, she had to use a wheelchair

|
|
audience
|
관객
The singer loves performing in front of an audience

|
|
clap
|
박수치다
We all clapped after the performers finished

|
|
concert
|
콘서트, 공연
The concert begins at 4:00, but we want to arrive early to get good seats

|
|
form
|
만들다
She formed a vase from clay
|
|
makeup
|
화장품
That woman wears a lot of makeup
|
|
monster
|
괴물
The little boy believes there is a monster under his bed

|
|
recognized
|
알아보는
We recognized the author from her picture on the back of the book
|
|
superstar
|
유명인사
Justin Bieber and Selena Gomez are superstars
|
|
adopt
|
입양하다, 쓰다
The school adopted a new music program this year
|
|
champion
|
챔피언
Jane wants to be a tennis champion one day

|
|
chess
|
체스
The old men like to meet in the park and play chess

|
|
disagree
|
반대하다
They disagreed over which kind of pizza to order
|
|
exam
|
시험
There is an English exam next Tuesday
|
|
grand master
|
그랜드 마스터(체스)
Ben will play chess with the grand master tomorrow
|
|
instructor
|
지도자
Lucy is the best art instructor I've ever had
|
|
mandatory
|
필수적인
In this country, school is mandatory until the age of 14
|
|
area
|
면적
There is snow covering the whole area
|
|
artifact
|
인공물
There are many interesting artifacts in the museum
|
|
chain
|
사슬
Darren locked his bike up with a big chain

|
|
coal
|
석탄
Let's put some more coal in the stove

|
|
dinosaur
|
공룡
The little boy's favorite book is about dinosaurs

|
|
footprint
|
발자국
The sea washed away the footprints in the sand

|
|
geologist
|
지질학자
The geologist was very interested in the rocks on the mountain
|
|
handprint
|
손자국
The child dipped her hand in paint and put a handprint on the wall
|
|
mud
|
진흙
Sharon stepped in a puddle and got mud all over her shoes

|
|
otherwise
|
아니면
Close the door, otherwise it will get cold in here
|
|
sticky
|
끈적거리는
I got some honey on my hands, and they were very sticky

|
|
athlete
|
운동선수
Jason is a great athlete and plays soccer and basketball well

|
|
base
|
루(야구)
He hit the ball and ran to first base

|
|
compete
|
경쟁하다
We are competing for the trophy
|
|
cooperation
|
협력
With your cooperation, we can finish all this work by tomorrow
|
|
goal
|
목표
Her goal is to save money so that she can go on vacation

|
|
gymnastics
|
체조
Susan has been doing gymnastics for 10 years
|
|
individual
|
개인의
That pizza shop makes small individual pizzas for lunch
|
|
sacrifice
|
희생하다
Troy's parents sacrificed a lot so that he could go to university
|
|
track
|
육상
Nate is on the high school track team

|
|
weightlifting
|
역도
Jim won the weightlifting competition
|
|
wrestling
|
레슬링
The two brothers are good at wrestling
|
|
bones
|
뼈
They found the bones of a cat in the forest

|
|
fake
|
가짜의
She bought her earrings for two dollars; they are fake gold
|
|
fragile
|
연약한
Don't drop that; it's very fragile
|
|
gullible
|
속이기 쉬운
gullible people will believe anything you tell them
|
|
mummy
|
미이라
There is an Egyptian mummy in the museum

|
|
sailor
|
선원
The sailors worked hard to keep the boat safe during the storm

|
|
scream
|
소리지르다
The child screamed when he fell down

|
|
shell
|
껍데기
Some chicken egg shells are white and others are brown

|
|
tail
|
꼬리
Dogs wag their tails from side to side when they are happy

|
|
wire
|
전선, 배선
He used wire to connect the two pieces together

|
|
carve
|
새기다
The artist is carving a beautiful picture into the rock
|
|
height
|
높이
The nurse will measure your height and weight
|
|
helmet
|
헬멧
We wear helmets when we ride bikes and skateboard

|
|
moment
|
순간
She went to the store, but she'll be back any moment
|
|
position
|
위치
The students at the front of the classroom were in the best position to see the science experiment
|
|
pyramid
|
피라미드
The ancient Egyptians built large pyramids many years ago

|
|
shadow
|
그림자
The kids used their hands and a flashlight to make fun shadows on the wall

|
|
spacecraft
|
우주선
The astronauts rode inside the spacecraft
|
|
surveyor
|
감정인
The surveyors made new maps of the surrounding area
|
|
broth
|
국
His mom made chicken broth for him when he was sick
|
|
dish
|
요리
They served a tasty dish with chicken and cheese in it

|
|
ingredient
|
재료
Some of the ingredients in the stew are potatoes and carrots

|
|
noodle
|
면
People eat a lot of noodles in Italy

|
|
nutty
|
견과류의
This milk has a nutty taste because it's made from almonds
|
|
starch
|
녹말
There is starch in bread
|
|
texture
|
감촉
Silk sheets have a smooth texture
|
|
wheat
|
밀
wheat bread is healthier than white bread

|
|
auditory
|
청각의
Listening to educational talks is good for auditory learners
|
|
combination
|
혼합물
A combination of red paint and blue paint gives us purple paint
|
|
organize
|
정리하다
David organized his books by subject
|
|
physical activity
|
신체 운동
Soccer and basketball are both physical activities
|
|
suit
|
맞다
Living in the country suits Max because he loves nature

|
|
tactile
|
촉감의
tactile books are often made for blind children to get them interested in reading
|
|
tip
|
조언
The accountant gave us some tips on how to save money

|
|
trace
|
테두리를 그리다
Jack couldn't draw a bear, but he traced one from a photograph in a magazine

|
|
visual
|
시각의
visual dictionaries are good for people who are beginning to learn a new language
|
|
bacteria
|
박테리아
Her sore throat was caused by bacteria
|
|
confident
|
자신있는
Tom is confident that his team will win

|
|
forgetful
|
까먹는
Grandpa is a bit forgetful these days
|
|
personality
|
성격
Katie has a very sweet personality
|
|
potentially
|
가능성 있게
Walking alone in the city late at night is potentially dangerous
|
|
sensible
|
합리적인
High heels are not very sensible shoes

|
|
sociable
|
사교적인
Dan is very sociable; he'll talk to anyone
|
|
stubborn
|
완고한
Max is too stubborn to admit that he is wrong

|
|
amusement
|
재미
To their amusement, the games were all fun
|
|
clip
|
동영상
There is a short clip about dogs that is funny
|
|
disgust
|
역겨움
You could see the disgust he felt by the expression on his face
|
|
emotion
|
감정
Even though he is angry, he shows no emotion
|
|
involve
|
관련있다
Getting there involves walking, riding the bus, and taking a taxi
|
|
lab
|
연구실
There is a lot of expensive equipment in the science lab

|
|
rate
|
평가하다
On a scale of one to ten, I rate this dessert a ten
|
|
scary
|
무서운
This movie is so scary!

|
|
scene
|
장면
The exciting scene takes place on top of a mountain

|
|
update
|
갱신하다
My computer updates itself periodically
|
|
diverse
|
다양한
The school has teachers from diverse backgrounds
|
|
instrument
|
악기
The violin, flute, and guitar are all musical instruments

|
|
log
|
통나무
They used the logs to build a fire

|
|
mold
|
모양을 변형시키다
The metal is heated and then molded into shape by hitting it

|
|
outfit
|
의상
They went shopping for new outfits
|
|
rattle
|
딸랑이
The baby loves to make noise by shaking his new rattle

|
|
rhythm
|
박자
The couple dances to the rhythm of the music

|
|
rubber
|
고무
The rubber ball bounces a lot

|
|
solo
|
혼자서
He wants to take a solo hiking trip across the mountains
|
|
steel
|
강철
The bridge is made of steel

|
|
strap
|
끈
Most backpacks have two straps
|
|
stretch
|
늘리다
These pants are comfortable because they stretch

|
|
ad
|
광고
There are so many ads on TV
|
|
aim
|
목적
Her aim is to get a better job this year
|
|
bite
|
물다
Someone took a bite out of my sandwich

|
|
field
|
분야
Professor Jones specializes in the field of ancient Egyptian history

|
|
image
|
이미지
He will always remember the image of his bride in her wedding dress
|
|
logo
|
로고
The Adidas logo has three stripes in the shape of a triangle
|
|
mermaid
|
인어
Helen thought she saw a mermaid in the ocean, but it was just some seaweed

|
|
modern
|
현대의
The latest phone on the market has the most modern technology
|
|
refreshing
|
상쾌한
We are thirsty and some refreshing ice water is just what we need

|
|
stand for
|
뜻하다
Everyone calls him J.P. which stands for John Paul
|
|
afford
|
여유가 되다
I'm saving up money so that I can afford to buy a new car

|
|
bug
|
벌레
There is a bug on the flower

|
|
compare
|
비교하다
If we compare these two shirts, we can see that one is slightly bigger than the other
|
|
cricket
|
귀뚜라미
Most crickets are black or brown, but some are green

|
|
diet
|
식습관
A vegetarian's diet has no meat in it

|
|
insect
|
곤충
Crickets, ants, and flies are insects, but spiders are not

|
|
nutrient
|
영양소
Plants get nutrients from the soil
|
|
picky
|
까다로운
Sarah is very picky about her friends
|
|
powder
|
가루
You can put this yellow powder in your drink and it will make you feel better

|
|
protein
|
단백질
Meat, cheese, and nuts are high in protein
|
|
worm
|
지렁이
worms are good for the soil

|
|
acre
|
에이커(면적단위)
There are two acres of fields behind our house
|
|
captive
|
사로잡힌
The pirates kept the captives at the back of the boat
|
|
capture
|
잡다
The veterinarian wants to capture the wounded cat in order to help it
|
|
chick
|
아기새
The chicks are learning to fly

|
|
extinct
|
멸종된
Dinosaurs have been extinct for many years
|
|
hatch
|
알을 까다
The sea turtles are hatching and soon they will make their way from the sand to the sea

|
|
nest
|
새 둥지
There is a bird's nest high up in the tree

|
|
pesticide
|
살충제
Fruits and vegetables grown without the use of pesticides are safer to eat
|
|
population
|
인구
The current population of Smithville is 350,000 people

|
|
release
|
풀다
Once the wolf's broken leg heals, we will release him into the wild

|